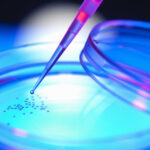

Protesta a Palermo dei disabili gravi che sperano di accedere al trattamento con cellule staminali mesenchimali del metodo Vannoni. Centinaia di persone hanno raggiunto il capoluogo siciliano e stanno manifestando. Il corteo partito da piazza Politeama è organizzato dal Movimento Vite Sospese e dalla onlus catanese Sicilia Risvegli, tra le prima in Italia a battersi per la cura con staminali.
Protesta a Palermo dei disabili gravi che sperano di accedere al trattamento con cellule staminali mesenchimali del metodo Vannoni. Centinaia di persone hanno raggiunto il capoluogo siciliano e stanno manifestando. Il corteo partito da piazza Politeama è organizzato dal Movimento Vite Sospese e dalla onlus catanese Sicilia Risvegli, tra le prima in Italia a battersi per la cura con staminali.
Davanti a Palazzo d’Orleans inizierà il “presidio ad oltranza – riferiscono gli organizzatori – sino a quando la Regione siciliana e il governo italiano non daranno risposte concrete ai manifestanti”. Ad aderire numerose associazioni regionali e nazionali, tra cui l’Admo. “Sì alla vita, sì a Stamina”, questa la richiesta precisa dei manifestanti che continuano a lottare per il diritto alle cure.
E non è un caso che l’appuntamento sia in Sicilia. Proprio nella nostra regione è arrivato uno stop inatteso: a fine luglio la Commissione sanità all’Ars aveva approvato una risoluzione con cui individuava le strutture sanitarie – l’ospedale Vittorio Emanuele di Catania e il Cervello di Palermo – dove sarebbe stato possibile sottoporsi a infusione di staminali. Poi il dietrofront.
Un nulla di fatto che ha suscitato lo sconforto dei malati, che lanciano accuse contro l’assessore regionale alla Salute, Lucia Borsellino che non li incontrerà prima del 13 novembre. “Per noi ogni minuto è fondamentale – dice Fabio Martino -. L’assessore ha spostato l’incontro di oltre 15 giorni e a porte chiuse, una vergogna”.
“Sono cardiopatico e ho deciso di sospendere le medicine – dice il presidente del movimento Base Italia, Rosario Martino-, perché l’assessore Borsellino ha rinviato al 13 novembre l’incontro con i malati e Vannoni, in programma per domani. Resterò qui in presidio ad oltranza: i malati non possono aspettare, chiediamo che la Regione autorizzi le cure con le cellule staminali”. In piazza a Palermo, alla manifestazione ha partecipato anche Sandro Biviano, che insieme al fratello dal 23 luglio scorso vive accampato davanti a Montecitorio per protestare contro le cure loro negate. Iniziative analoghe sono state organizzate dal movimento anche a Catania e Modica, nel Ragusano.












